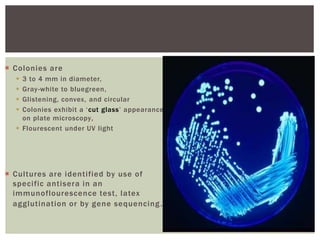
 Colonies are
 3 to 4 mm in diameter,
 Gray-white to bluegreen,
 Glistening, convex, and circular
 Colonies exhibit a ‘cut glass’ appearance
on plate microscopy,
 Flourescent under UV light
 Cultures are identified by use of
specific antisera in an
immunoflourescence test, latex
agglutination or by gene sequencing.
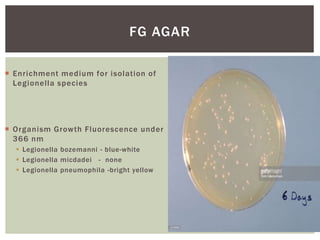
 Enrichment medium for isolation of
Legionella species
 Organism Growth Fluorescence under
366 nm
 Legionella bozemanni - blue-white
 Legionella micdadei - none
 Legionella pneumophila -bright yellow
FG AGAR

This document provides information on Legionella, including its classification, species that cause human infections, reservoirs, transmission, clinical manifestations, diagnosis and treatment. Legionella is a genus of bacteria that can cause Legionnaires' disease or Pontiac fever in humans. L. pneumophila serogroup 1 is responsible for the majority of infections. Legionella is commonly found in water systems and can infect humans when contaminated water droplets are inhaled. Diagnosis involves urine antigen testing, culture, staining and PCR. Treatment involves antibiotics such as macrolides or fluoroquinolones. Preventing Legionella growth in water systems is key to preventing infections.